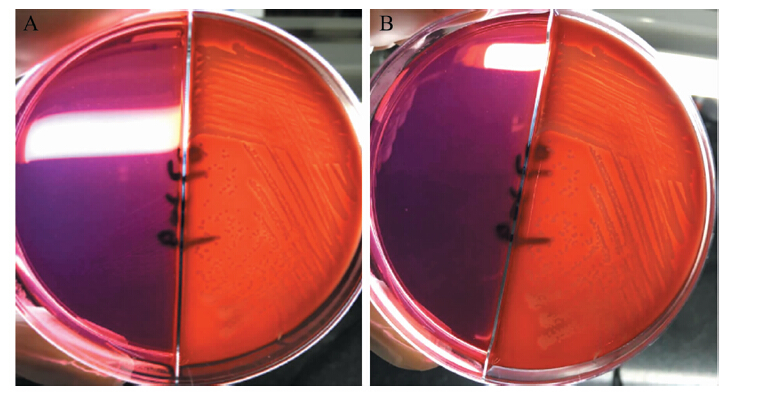

慢性骨髓炎指骨组织的慢性感染,由外伤、交通伤等高能量损伤特别是开放性骨损伤未经彻底清创或虽经彻底清创但创伤及污染较重或由手术时无菌操作不严格所引起。慢性骨髓炎因其死骨、窦道、死腔及病变肉芽组织的长期存在,治疗较困难,是困扰骨科医师的难题[1]。目前,临床上对于慢性骨髓炎主要采用彻底清创、含抗生素液体灌洗髓腔疗法以及静脉滴注抗生素4~6周的治疗方案,但在临床上因为种种原因,慢性骨髓炎易反复发作,有报道指其复发率达20%~30%[2-3]。长期使用抗生素也容易使细菌产生耐药性[4]。本研究使用兔慢性骨髓炎胫骨模型,比较蒸馏水煮沸、碘伏浸泡及抗生素冲洗3种不同方法的灭菌效果,旨在为慢性骨髓炎彻底清创后灭菌方法的选择提供依据,现报告如下。
材料与方法 一. 实验动物健康状况良好的50只新西兰大白兔,体质量2.0~2.5 kg,雄性24只、雌性26只,由承德医学院动物实验中心提供,术前以等量饲料常规喂养2周。实验过程中对动物饲养和处置符合医学伦理学标准。
二. 主要试剂金黄色葡萄球菌由承德医学院附属医院检验科提供,制成浓度为1×106 cfu/ml菌液备用。5%鱼肝油酸钠为上海金珠药业有限公司产品。
三. 方法 1 兔胫骨骨髓炎模型制作使用乌拉坦8 ml腹腔注射麻醉实验兔,然后于右胫骨内侧近端备皮,大小范围约4 cm2,备皮完成后取右胫骨内侧作一4 cm长的纵切口,用无菌手术刀切开皮肤和皮下组织,暴露右胫骨近端内侧,钝性剥离约2 cm×2 cm大小的骨膜,取用3 mm钻头的电钻,只穿透一侧皮质,在分离的骨膜处钻9个等大骨洞,再用直径1 cm的磨钻,制成一个约1.5 cm×1.0 cm的椭圆形骨缺损即骨窗(图 1)。然后用小刮匙分别沿骨窗远、近端刮除部分松质骨,完成后以0.9%生理盐水5 ml冲洗远近端髓腔。取用金黄色葡萄球菌液1 ml,摇匀,用一次性滴定管吸取0.5 ml的金黄色葡萄球菌液从骨窗内向髓腔内沿远、近端注入,静置5 min,待菌液充分扩散,再向骨窗内沿远近端注射0.5 ml的5%鱼肝油酸钠,用生理盐水反复冲洗伤口后逐层缝合皮肤。 术毕,回笼常规喂饲4周。整个过程中,实验兔因麻醉致死1只,术后细菌感染死亡1只。

|
图 1 1.5 cm×1.0 cm的椭圆形骨窗 |
试验后兔子均出现不同程度发热、精神差、进食少等表现,均为骨髓炎后的临床表现,术后4周内死亡1只。术后4周,将存活的47只兔行X线摄片检查,47只兔从肉眼观察均呈现出局部软组织肿胀,其中38只有破溃表现,骨质破坏,增生的骨痂,且有死骨形成(图 2A、B)。检测回报有2只兔为假阳性模型,其余45只兔满足诊断标准可作为兔胫骨骨髓炎模型行下一步实验。
3 分组将造模成功的45只兔编号,分别应用空气栓塞处死后取出右胫骨的骨髓炎病骨,每段均包含着病变胫骨及肉眼观察无明显改变的胫骨0.5 cm(图 2C),总共45例,采用随机数字表法,分为A、B、C组,每组各15例。整个过程严格遵守随机分配原则。

|
图 2 兔胫骨骨髓炎模型 A:兔胫骨骨髓炎造模4周后,可见明显骨缺损及大量骨痂形成;B:造模成功后图胫骨原切口处可见破溃,少量淡黄色液体渗出;C:空气栓塞法处死后右胫骨大体标本,局部死骨形成,可见明显窦道 |
A组:在标准大气压下、超净工作台上,取1个100 ml烧杯倒入50 ml蒸馏水,待烧杯中蒸馏水达到沸点,在刚沸腾瞬间调节酒精灯大小,使其保持煮沸状态,截取15例实验兔的慢性骨髓炎胫骨2 cm,均为完整包含病骨且含部分正常胫骨组织,分别置于50 ml蒸馏水的烧杯中30 min。
B组:取15个无菌换药包,将新启碘伏倒满无菌弯盘内,按前述方法截取病骨,置入无菌弯盘内,充分浸泡约30 min,然后用0.9%生理盐水100 ml彻底冲洗。
C组:取出病骨后,用庆大霉素80 kU溶于500 ml生理盐水制成抗生素溶液灌洗病骨。第1~3日每日冲洗6 L,第4~9日冲洗3 L,第10~14日冲洗1.5 L,最后1次抗生素溶液冲洗后应用0.9%生理盐水冲洗。
四. 观察内容观察3组兔胫骨有无破损、皮质断裂等,确定3种处理方法对其有无物理破坏,然后将病骨分为2部分,一部分送细菌室 ( 间隔时间不超过2 h),于常规培养皿在35℃恒温箱内培养48 h,在高倍显微镜下观察有无菌落形成及菌落数目;另一部分制成切片后行病理学检查,观察是否存在嗜酸性粒细胞等炎症细胞浸润影、组织水肿影、成骨细胞及死骨形成等。
五. 统计学处理采用SPSS 19.0统计软件。计数资料以百分比表示,采用χ2检验。总体比较以P<0.05为差异有统计学意义,组间两两比较采用Bonferroni法校正,以P<0.05/3=0.017为差异有统计学意义。
采用SPSS 19.0统计软件。计数资料以百分比表示,采用χ2检验。总体比较以P<0.05为差异有统计学意义,组间两两比较采用Bonferroni法校正,以P<0.05/3=0.017为差异有统计学意义。
结果 一. 大体观察3组兔胫骨经杀菌处理后,均未出现骨皮质碎裂,均能保持较好的形态,肢体长度及力学轴线较健侧无明显异常。
二. 细菌学培养A组骨缺损周围组织细菌培养可见明显菌落形成1例,阳性率为7%;B组可见明显菌落形成4例,阳性率为27%;C组可见明显菌落形成7例,阳性率为47%。3组的阳性率比较差异有统计学意义(χ2=8.005,P=0.019);进一步两两比较显示,A、C组的阳性率比较差异有统计学意义(χ2=7.778,P=0.005),见图 3。
|
图 3 细菌培养结果 A:左边为A组,右边为B组细菌学培养阳性者,B:左边为A组,右边为C组细菌学检测阳性者 |
高倍显微镜下,A组可见骨组织无明显水肿,大片死骨形成,呈片状或条带状,伴或不伴有少量成骨母细胞,呈零星点状分布,未见明显分布规律,其中1例稀疏凌乱排列着少量嗜酸性粒细胞,见图 4。B组均可见骨组织轻度水肿,无死骨形成,其中4例可见大块区域的嗜酸性粒细胞浸润,面积较大伴组织水肿,符合慢性骨髓炎改变,且成骨细胞更稀疏,见图 5。C组可见组织肿胀,成骨细胞散在分布,其中8例可见大块区域的嗜酸性粒细胞浸润性生长,面积较大,组织明显水肿,细胞成分较为混乱,见图 6。病理学检测结果与细菌学结果相符。

|
图 4 经蒸馏水煮沸杀菌的兔慢性骨髓炎胫骨组织病理学检查结果(苏木素-伊红染色,A×100、B×50)片状或条带状明显死骨形成(箭头所指),但未见嗜酸性粒细胞等炎症细胞存在 |

|
图 5 经碘伏浸泡杀菌的兔慢性骨髓炎胫骨组织病理学检查结果(苏木素-伊红染色,A×100、B×200) A:大块区域的嗜酸性粒细胞浸润,面积较大,组织轻度水肿,符合慢性骨髓炎改变;B:少量稀疏的成骨细胞存在 |

|
图 6 经抗生素冲洗杀菌的兔慢性骨髓炎胫骨组织病理学检查结果(苏木素-伊红染色,×100) 大面积的嗜酸性粒细胞浸润性生长,组织明显水肿,细胞成分较为混乱 |
慢性骨髓炎因其难以根治,具有较高的致死致残率,且发病率逐年上升[5]。近年来国内外学者曾提出过多种慢性骨髓炎的治疗方法,包括药物治疗和冲洗、肌瓣填塞、骨搬移等特殊手段,但效果欠佳[6]。邹林等(2008年)提出,慢性骨髓炎外科手术应在术中使用苯扎溴铵浸泡创面10 min杀灭残存细菌,创口用3%双氧水冲洗。徐建强等[7]应用2%碘伏纱布塞入缺损区浸泡5 min,再联合大量生理盐水 冲洗清除病灶。喻胜鹏等[8]认为骨重建是感染性 骨缺损治疗的关键,只有骨具备重建能力,才能达到彻底清创的目的。
在临床实际应用中,抗生素冲洗带来了诸多严重问题,诸如二次感染、易致肝肾损伤、菌群失调等,更为严重的是会产生耐药性,目前有淘汰的趋势[9]。碘伏是当前国际上较为公认的高效、广谱、无毒的杀菌剂[10]。碘伏对局部组织如神经、肌肉、血管等无明显刺激和破坏,用来灌洗可在短时间内渗入死腔、病骨及周围瘢痕组织,快速、彻底杀灭残存其中的细菌,更为重要的是针对死骨形成的“细菌保护伞”,于病灶骨表面形成杀菌膜,通过产生游离碘,进而使细菌细胞膜被氧化而使其失活、无法复制,迅速杀灭致病微生物菌群[11]。 李安明等[12]报道,慢性骨髓炎患者行碘伏灌洗后的CRP水平明显低于抗生素冲洗后,碘伏灌洗可有效降低慢性骨髓炎的术后感染率。本研究显示,碘伏浸泡具有良好的杀菌效果,优于抗生素治疗。但是,碘伏亦存在不利因素,如碘伏换药后无菌敷料物干燥后易发生换药部位粘连,若强行撕扯容易导致手术切口皮缘掀起,造成患肢渗血甚至大出血,再次换药时易造成机械性损伤,而且无法引流切口内积液,易引起伤口感染,其次碘伏制剂对人体正常生物组织有一定的毒性作用,不利于切口组织的生长[10]。
对于慢性骨髓炎,临床上彻底清除感染灶后,若骨缺损较大,处理十分棘手。同样的问题出现在恶性骨肿瘤 (骨肉瘤) 患者中,其治疗方式之一就是肿瘤骨切除、灭活、回植。病骨灭活原位移植技术是治疗慢性骨髓炎的新技术。贝朝涌等 (2012年) 采用感染骨灭活原位移植治疗慢性骨髓炎患者,将感染骨煮沸后原位移植,术后8周移植骨与截骨断面间隙有血管长入,骨小梁散在发育,大量软骨细胞团形成,认为灭活后的感染骨可作为骨支架,具有抗感染及促进成骨的双重作用,治疗慢性骨髓炎效果良好。本研究采用兔胫骨慢性骨髓炎模型,应用3种不同方法对病骨进行杀菌处理,处理后的胫骨病骨均无明显骨皮质劈裂,且符合肢体力学轴线,蒸馏水煮沸与碘伏浸泡在杀菌效果上均优于抗生素冲洗法,且处理后的组织病理学检查仍可见成骨母细胞。 结果表明,蒸馏水煮沸对兔胫骨慢性骨髓炎的病骨杀菌效果良好,如将该法应用于临床将大幅降低治疗成本,且方法简便,易于开展、无药物相关不良反应,有较大的发展空间及应用价值。
| [1] | 汪小华, 傅景曙, 沈杰, 谢肇. 膜诱导技术治疗胫骨创伤后骨髓炎[J]. 中华创伤杂志, 2015, 31 (4): 299-302. |
| [2] | Polyzois VD, Stathopoulos IP, Lampropoulou-Adamidou K, Vasiliadis ES, Vlamis J, Pneumaticos SG. Strategies for managing bone defects of the lower extremity[J]. Clin Podiatr Med Surg, 2014, 31 (4): 577-584. DOI: 10.1016/j.cpm.2014.06.008. |
| [3] | Jeong JJ, Lee HS, Choi YR, Kim SW, Seo JH. Surgical treatment of non-diabetic chronic osteomyelitis involving the foot and ankle[J]. Foot Ankle Int, 2012, 33 (2): 128-132. DOI: 10.3113/FAI.2012.0128. |
| [4] | McNally MA, Ferguson JY, Lau AC, Diefenbeck M, Scarborough M, Ramsden AJ, Atkins BL. Single-stage treatment of chronic osteomyelitis with a new absorbable, gentamicin-loaded, calcium sulphate/hydroxyapatite biocomposite: a prospective series of 100 cases[J]. Bone Joint J, 2016, 98-B (9): 1289-1296. DOI: 10.1302/0301-620X.98B9.38057. |
| [5] | 章晓云, 陈跃平, 龙飞攀, 康杰, 董盼锋, 饶毅, 袁振中. 抗生素骨水泥治疗创伤性胫骨骨髓炎的临床疗效分析[J]. 中国骨与关节损伤杂志, 2015, 30 (4): 371-373. |
| [6] | 段建伟, 魏俊强, 张猛, 闫石. 外固定架加压-牵开-再加压治疗非感染性骨折不愈合实验研究[J]. 新医学, 2016, 47 (5): 318-323. |
| [7] | 徐建强, 周密, 樊丽洁, 姚军, 郝国兵, 李波, 张树明. 抗生素骨水泥填塞治疗慢性跟骨骨髓炎[J]. 中国骨与关节损伤杂志, 2014, 29 (10): 1070-1071. |
| [8] | 喻胜鹏. Masquelet技术与Ⅰ期骨移植治疗下肢创伤后骨髓炎的疗效比较.2014,第三军医大学. |
| [9] | 王军, 李宗原, 王陶. 慢性骨髓炎保肢治疗现状及进展[J]. 中国骨科临床与基础研究杂志, 2014, 10 (5): 301-306. |
| [10] | 胡庆常, 刘斌. 碘伏消毒联合乙醇湿敷预防肥胖患者术后切口感染的疗效观察[J]. 吉林医学, 2012, 33 (19): 4118-4119. |
| [11] | 范兰兰. 碘伏消毒加红外线照射在褥疮患者中的应用[J]. 中国伤残医学, 2014, 22 (1): 231-231. |
| [12] | 李安明, 韩晓强. 抗生素灌洗与碘伏灌洗疗法治疗慢性骨髓炎的对比研究[J]. 临床和实验医学杂志, 2016, 15 (2): 132-134. |



